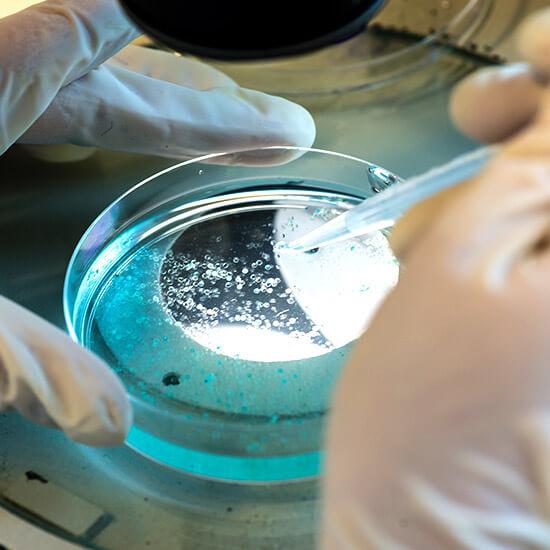
생명과학전공은 생명 현상의 다양한 수준, 즉 분자, 세포, 조직, 기관, 개체, 개체군 등으로 발전하는 체계적 현상의 작동 메커니즘과 기능 에 대한 이론과 원리를 터득하고 능동적인 응용과 창의적인 연구능력 을 지닌 선도적 연구 및 기술 인력을 양성한다.

비주얼(2 개)
-

비주얼 1
비주얼 1
-

비주얼 2
비주얼 2
사람과 자연이 함께 행복할 수 있는 교육과 연구를 실천하는
생명과학기술대학
국가 경쟁력 제고에 기여할 수 있는 바이오산업 맞춤형, 주도형, 그리고 창출형 인재를 양성합니다.
전공소개(4 개)


-
생명과학기술대학 생명과학 전공
생명과학전공은 생명 현상의 다양한 수준, 즉 분자, 세포, 조직, 기관, 개체, 개체군 등으로 발전하는 체계적 현상의 작동 메커니즘과 기능 에 대한 이론과 원리를 터득하고 능동적인 응용과 창의적인 연구능력 을 지닌 선도적 연구 및 기술 인력을 양성한다.
-
생명과학기술대학 분자의생명 전공
분자의생명전공은 과학적 사고력과 독창적인 탐구력을 길러주고 기초의과학의 학문발전에 기여할 과학자를 발굴 양성 한다. 나아가 합리적인 사고력을 갖고 과학적 생활을 영위하며 의학 분야에서 지도적 역할을 수행할 수 있는 훌륭한 소양을 지닌 인력을 양성한다.

-
생명과학기술대학 생명공학
생명공학은 생명과학 기초지식을 토대로 새로운 바이오 소재와 기술을 개발하는 응용 학문으로, 바이오의약, 제약, 화학, 식품, 화장품, 환경, 에너지 등 21세기 첨단 바이오산업과 4차 산업혁명을 선도할 핵심 분야입니다. 생명공학전공에서는 세포, 생체 조직, 생물 개체, 유전자, 단백질, 대사산물 등 다양한 바이오 소재와 생명 현상에 대한 체계적인 교육 과정과 시스템을 학생들에게 제공합니다. 이를 통해 궁극적으로는 국가 과학 기술 성장 동력과 경쟁력 증진을 선도할 역량 있는 실무 인재와 공학자를 양성하고자 합니다.

-
생명과학기술대학 나노바이오
나노바이오전공은 21세기 첨단과학의 원천기술이며 국가신성장동력 창출산업의 기반기술인 나노기술분야의 전문지식을 함양시키고, BT, IT, NT기술이 융합된 나노시스템 및 나노바이오 기술분야에서 요구되는 산업전문인력 및 미래기술 발전에 기여할 수 있는 고급핵심인재를 양성하기 위하여 설립된 학과이다.

-

- 생명과학 기술대학 홍보영상
- 생명과학기술대학에서는 바이오 특성화 교육 및 연구 시스템을 구축하여 국가 바이오산업에 중추적 역할수행과 핵심 인재 양성에 노력하고 있습니다.
-

- 생명과학 전공 홍보영상
- 생명과학 전공 기본역학(analytical mechanics)-공업역학(정역학, 동역학), 고체역학, 유체역학, 열역학과 이를 응용한 설계(design), 생산(manufacturing)
-

- 분자의생명 전공 홍보영상
- 분자의생명 전공 기본역학(analytical mechanics)-공업역학(정역학, 동역학)
-

- 생명공학 전공 홍보영상
- 생명공학 전공 기본역학(analytical mechanics)-공업역학(정역학, 동역학), 고체역학, 유체역학, 열역학과 이를 응용한 설계(design), 생산(manufacturing) 및 로봇공학 분야 응용의 전 과정에 이르는 광범위한 분야를 다루는 창의적인 종합 예술적 학문이다.
-

- 나노바이오 전공 홍보영상
- 나노바이오 전공 기본역학(analytical mechanics)-공업역학(정역학, 동역학), 고체역학, 유체역학, 열역학과 이를 응용한 설계(design), 생산(manufacturing) 및 로봇공학 분야 응용의 전 과정에 이르는 광범위한 분야를 다루는 창의적인 종합 예술적 학문이다.
-

- 에너지화학 공학과 홍보영상
- 에너지화학 공학과 기본역학(analytical mechanics)-공업역학(정역학, 동역학), 고체역학, 유체역학, 열역학과 이를 응용한 설계(design), 생산(manufacturing) 및 로봇공학 분야 응용의 전 과정에 이르는 광범위한 분야를 다루는 창의적인 종합 예술적 학문이다.
-

- 나노바이오 공학과 홍보영상
- 에너지화학 공학과 기본역학(analytical mechanics)-공업역학(정역학, 동역학), 고체역학, 유체역학, 열역학과 이를 응용한 설계(design), 생산(manufacturing) 및 로봇공학 분야 응용의 전 과정에 이르는 광범위한 분야를 다루는 창의적인 종합 예술적 학문이다.
-
연구분야(4 개)
-

미생물유전공학
미생물유전공학
-

바이오의약 개발
바이오의약 개발
-

핵산나노 기술
핵산나노 기술
-

나노바이오
나노바이오
-
더보기READ MORE
-
원우회비(선택경비)는 선택사항이며, 만약에 납부를 원할 시 등록금과 꼭 합산하여 납부원우회비(선택경비)는 선택사항이며, 만약에 납부를 원할 시 등록금과 꼭 합산하여 납부원우회비(선택경비)는 선택사항이며, 만약에 납부를 원할 시 등록금과 꼭 합산하여 납부원우회비(선2023.06.1919 2023.06
-
2023년 국가우수장학금(이공계) 재학중우수자 장학생 선발 안내...2023년 국가우수장학금(이공계) 재학중우수자 장학생 선발 안내...2023년 국가우수장학금(이공계) 재학중우수자 장학생 선발 안내...2023년 국가우수장학금(이공계) 재학중우수2023.06.1919 2023.06
-
통합정보시스템→학사행정→등록→고지서출력통합정보시스템 학사행정 등록 고지서출력통합정보시스템 학사행정 등록 고지서출력통합정보시스템 학사행정 등록 고지서출력통합정보시스템 학사행정 등록 고지서출력2023.06.1919 2023.06
-
등록금을 납부하면 학사정보에 등록되어 있는 학생의 휴대전화로 문자메세지가 전송되오니 전화번호가 변경된 경우 반드시 정정등록금을 납부하면 학사정보에 등록되어 있는 학생의 휴대전화로 문자메세지가 전송되오니 전화번호가 변경된 경우 반드시 정정등록금을 납부하면 학사정보에 등록되어 있는 학생의 휴대전화로2023.06.1919 2023.06
-
원우회비(선택경비)는 선택사항이며, 만약에 납부를 원할 시 등록금과 꼭 합산하여 납부원우회비(선택경비)는 선택사항이며, 만약에 납부를 원할 시 등록금과 꼭 합산하여 납부원우회비(선택경비)는 선택사항이며, 만약에 납부를 원할 시 등록금과 꼭 합산하여 납부원우회비(선2023.06.1919 2023.06
-
학자금대출자는 등록금납부기간 내 반드시 ‘대출실행‘을 하시기 바랍니다.학자금대출자는 등록금납부기간 내 반드시 대출실행 을 하시기 바랍니다.학자금대출자는 등록금납부기간 내 반드시 대출실행 을 하시기 바랍니다.학자금대출자는 등록금납부기간 내 반드시2023.06.1919 2023.06
-
[4차 산업혁명의 이해와 융합 교과목 개발을 위한 전문가 초청 특별 강의][4차 산업혁명의 이해와 융합 교과목 개발을 위한 전문가 초청 특별 강의]2023.06.1919 2023.06
-
교육용 클라우드 메신저 (카카오워크) 서비스 사용 안내교육용 클라우드 메신저 (카카오워크) 서비스 사용 안내교육용 클라우드 메신저 (카카오워크) 서비스 사용 안내교육용 클라우드 메신저 (카카오워크) 서비스 사용 안내교육용 클라우드 메2023.06.1919 2023.06
-
2023년 상반기 연구활동조사자 온라인 안전교육2023년 상반기 연구활동조사자 온라인 안전교육2023.06.1919 2023.06
-
2023년도 전공취업동아리 모집 안내2023년도 전공취업동아리 모집 안내2023년도 전공취업동아리 모집 안내2023년도 전공취업동아리 모집 안내2023년도 전공취업동아리 모집 안내2023.06.1919 2023.06
1 -
-
더보기READ MORE
- 최근게시물이(가) 없습니다.
1 -
더보기READ MORE
- 최근게시물이(가) 없습니다.
1











